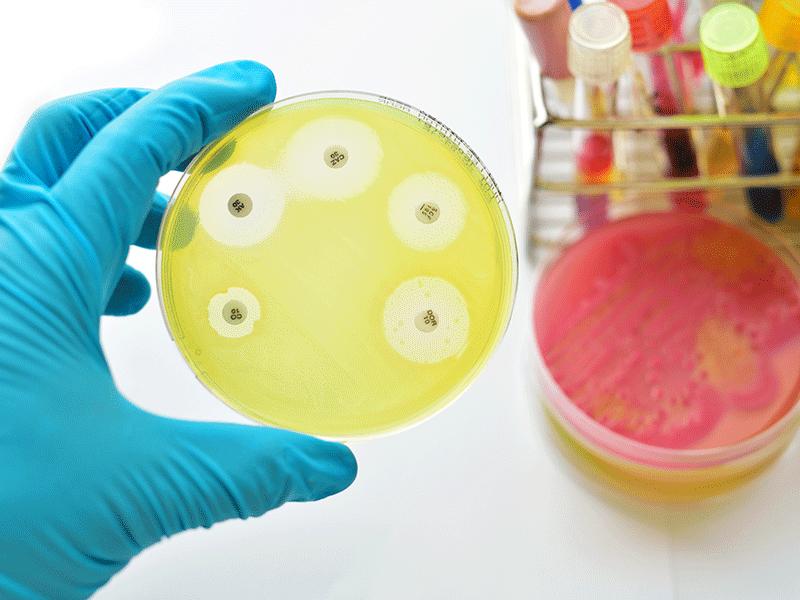

Press release
Peripheral Neuropathy Market Outlook: Innovations, Insights & Growth Drivers | Major Companies are GlaxoSmithKline, Abbott Laboratories, Cipla Laboratories, Novartis AG.
Peripheral Neuropathy Market size was valued US$ 1,539 million in 2021 and is estimated to reach US$ YY million by 2031, growing at a CAGR of 4.2% during the forecast period (2024-2031).The Peripheral Neuropathy Market takes center stage in DataM Intelligence's latest comprehensive research, where industry experts deliver cutting-edge analysis powered by robust data analytics and strategic market intelligence. This groundbreaking study dives deep into the competitive ecosystem, spotlighting market leaders and their innovative approaches to product development, competitive pricing models, financial performance, and expansion strategies. The research unveils critical market forces, competitive positioning, and breakthrough trends that will define the industry's trajectory in the coming years, providing stakeholders with actionable intelligence to navigate this rapidly evolving marketplace.
Unlock exclusive insights with our detailed sample report (Please enter your Corporate Email ID to get priority access):- https://datamintelligence.com/download-sample/peripheral-neuropathy-market?rk
The growing use of chemotherapy drugs and rising incidence of chronic diseases are key drivers of market expansion.
The peripheral neuropathy market is witnessing notable growth, fueled by the increasing prevalence of diabetes, the rising administration of chemotherapy drugs for cancer treatment, and greater awareness surrounding peripheral neuropathy. According to the International Diabetes Federation (2020), approximately 493 million adults aged 20-79 were living with diabetes globally a figure projected to reach 700 million by 2045. Diabetic individuals are at a heightened risk of developing diabetes-induced peripheral neuropathy.
Studies indicate that 7% to 18% of adults now suffer from chronic neuropathic pain, with an estimated incidence of 1,000 cases per 100,000 people annually. In the UK alone, 26% of people with diabetes report experiencing peripheral neuropathic pain. These trends are expected to significantly propel the growth of the peripheral neuropathy market during the forecast period.
Furthermore, increasing mergers, acquisitions, and collaborations among leading pharmaceutical companies are opening doors to new markets and innovative treatments. For example, in February 2019, Teva Pharmaceutical Industries Ltd. launched a generic version of Sabril tablets in the U.S. market. With a portfolio of over 550 generic medications, Teva leads in FDA-approved generics and maintains a dominant position in first-to-file opportunities. Notably, one of the serious side effects of this drug includes peripheral neuropathy, underlining the importance of ongoing monitoring and innovation in this treatment area.
Peripheral Neuropathy Market: Industry Giants and Emerging Leaders:
GlaxoSmithKline, Abbott Laboratories, Cipla Laboratories, Novartis AG, Merck and Co., Bristol Meyer Squibb, Reddy's Lab, Pfizer and Elli Lilly and Company, Eli Lilly.
Peripheral Neuropathy Industry News:
In March 2021, Averitas Pharma announced the initiation of a Phase III clinical trial to evaluate the efficacy and safety of QUTENZA in treating post-surgical neuropathic pain.
Research Methodology
Our comprehensive research approach leverages a dual-methodology framework that seamlessly integrates qualitative insights with quantitative data analysis to deliver robust market intelligence. The process begins with extensive secondary research, where we meticulously collect information from authoritative industry publications, proprietary databases, and verified market sources. This foundation is strengthened through targeted primary research initiatives, including strategic surveys and in-depth interviews with industry veterans, market experts, and key stakeholders.
Speak to Our Senior Analyst and Get Customization in the report as per your requirements: https://datamintelligence.com/customize/peripheral-neuropathy-market
Segment Covered in the Peripheral Neuropathy Market:
By Type (Diabetic Peripheral Neuropathy, Chemotherapy-induced Peripheral Neuropathy, Idiopathic Peripheral Neuropathy Natural Colorants, HIV/AIDS Associated Peripheral Neuropathy, Others.
By Treatment (Pharmacological Therapies, Non-Pharmacological Therapies, Physical Therapies, Surgery, Others.
By End-User (Hospitals, Clinics, Ambulatory Centers, Others
This Report Covers:
✔ Go-to-market Strategy.
✔ Neutral perspective on the market performance.
✔Development trends, competitive landscape analysis, supply side analysis, demand side analysis, year-on-year growth, competitive benchmarking, vendor identification, Market Access, and other significant analysis, as well as development status.
✔Customized regional/country reports as per request and country level analysis.
✔ Potential & niche segments and regions exhibiting promising growth covered.
✔ Top-down and bottom-up approach for regional analysis
Regional Analysis for Peripheral Neuropathy Market:
⇥ North America (U.S., Canada, Mexico)
⇥ Europe (U.K., Italy, Germany, Russia, France, Spain, The Netherlands and Rest of Europe)
⇥ Asia-Pacific (India, Japan, China, South Korea, Australia, Indonesia Rest of Asia Pacific)
⇥ South America (Colombia, Brazil, Argentina, Rest of South America)
⇥ Middle East & Africa (Saudi Arabia, U.A.E., South Africa, Rest of Middle East & Africa)
Frequently asked questions:
➠ What is the global sales value, production value, consumption value, import and export of Peripheral Neuropathy market?
➠ Who are the global key manufacturers of the Peripheral Neuropathy Industry? How is their operating situation (capacity, production, sales, price, cost, gross, and revenue)?
➠ What are the Peripheral Neuropathy market opportunities and threats faced by the vendors in the global Peripheral Neuropathy Industry?
➠ Which application/end-user or product type may seek incremental growth prospects? What is the market share of each type and application?
➠ What focused approach and constraints are holding the Peripheral Neuropathy market?
➠ What are the different sales, marketing, and distribution channels in the global industry?
Stay informed with the latest industry insights-start your subscription now: https://www.datamintelligence.com/reports-subscription
Looking For Detailed Full Report? Get it here: https://datamintelligence.com/buy-now-page?report=peripheral-neuropathy-market
Contact Us -
Company Name: DataM Intelligence
Contact Person: Sai Kiran
Email: Sai.k@datamintelligence.com
Phone: +1 877 441 4866
Website: https://www.datamintelligence.com
About Us -
DataM Intelligence is a Market Research and Consulting firm that provides end-to-end business solutions to organizations from Research to Consulting. We, at DataM Intelligence, leverage our top trademark trends, insights and developments to emancipate swift and astute solutions to clients like you. We encompass a multitude of syndicate reports and customized reports with a robust methodology.
Our research database features countless statistics and in-depth analyses across a wide range of 6300+ reports in 40+ domains creating business solutions for more than 200+ companies across 50+ countries; catering to the key business research needs that influence the growth trajectory of our vast clientele.
This release was published on openPR.
Permanent link to this press release:
Copy
Please set a link in the press area of your homepage to this press release on openPR. openPR disclaims liability for any content contained in this release.
You can edit or delete your press release Peripheral Neuropathy Market Outlook: Innovations, Insights & Growth Drivers | Major Companies are GlaxoSmithKline, Abbott Laboratories, Cipla Laboratories, Novartis AG. here
News-ID: 4068208 • Views: …
More Releases from DataM Intelligence 4market Research LLP
Global Antimicrobial Therapeutics Market Trends: Drug Innovation, Clinical Trial …
The global antimicrobial therapeutics market reached US$ 96.13 billion in 2023 and is expected to reach US$ 148.16 billion by 2031, growing at a CAGR of 5.64% during the forecast period 2024-2031.
The Antimicrobial Therapeutics Market involves drugs and treatments that inhibit or kill pathogens like bacteria, fungi, and viruses. Growth is driven by rising infectious disease prevalence, antimicrobial resistance, and healthcare demand. Classes include antibiotics, antivirals, antifungals, and monoclonal antibodies.…

Europe mRNA Vaccine Market to Reach USD 43.2 Billion by 2031 Driven by Advances …
According to DataM Intelligence, the Europe mRNA Vaccine Market is projected to grow from USD 13.6 billion in 2025 to USD 43.2 billion by 2031, registering a rapid CAGR of 21.1% during the forecast period. The region's strong focus on vaccination programs, public health resilience, and biotechnology innovation is fueling the adoption of messenger RNA (mRNA)-based vaccine platforms. The success of the COVID-19 vaccines from Pfizer-BioNTech and Moderna validated the…

Ebola Virus Infection Market Outlook 2024-2031: Antiviral Drugs, Monoclonal Anti …
Ebola Virus Infection Market is valued at a significant CAGR during the forecast period (2024-2031). As per DataM Intelligence Database.
The Ebola Virus Infection Market focuses on therapies, vaccines, and diagnostic tools for Ebola virus disease. Growth is driven by recurring outbreaks in Africa and increasing global health preparedness. Treatments include antiviral drugs, monoclonal antibodies, and supportive care. Vaccine development, like rVSV-ZEBOV, has improved prevention. Diagnostic advancements enable rapid detection and…

Battery as a Service Market to Reach USD 14.45 Billion by 2035 Driven by EV Flee …
According to DataM Intelligence, the Global Battery as a Service (BaaS) Market is projected to grow from USD 0.66 billion in 2024 to USD 14.45 billion by 2035, advancing at a remarkable CAGR of 32.4% during the forecast period. The surge in electric vehicle (EV) adoption, particularly in commercial fleets, logistics, and public transportation, is driving the demand for battery leasing and swapping solutions. As EV ownership models evolve, the…
More Releases for Peripheral
Peripheral Vascular Devices Market - Advancing vascular health: Cutting-edge dev …
Newark, New Castle, USA: The "Peripheral Vascular Devices Market" provides a value chain analysis of revenue for the anticipated period from 2022 to 2030. The report will include a full and comprehensive analysis of the business operations of all market leaders in this industry, as well as their in-depth market research, historical market development, and information about their market competitors
Peripheral Vascular Devices Market: https://www.growthplusreports.com/report/peripheral-vascular-devices-market/7820
This latest report researches the industry structure,…
Peripheral Stent Market - Pioneering Solutions for Peripheral Artery Disease: Re …
Newark, New Castle, USA - Growth Plus Reports has published a new report on Peripheral Stent Market, which includes a detailed analysis based on competitors and important market segments (2023-2031). The Global Peripheral Stent provides a thorough analysis of many segments such as opportunities, market size, developments, innovation, sales, and overall growth of leading players. The research is based on primary and secondary statistical data, and it includes both intuitive…
Peripheral Vascular Devices Market - Empowering Mobility, Preserving Health: Ele …
Newark, New Castle, USA - new report, titled Peripheral Vascular Devices Market The report has been put together using primary and secondary research methodologies, which offer an accurate and precise understanding of the Peripheral Vascular Devices market. Analysts have used a top-down and bottom-up approach to evaluate the segments and provide a fair assessment of their impact on the global Peripheral Vascular Devices market. The report offers an overview of…
Peripheral Vascular Devices Market Report 2018: Segmentation by Types (Periphera …
Global Peripheral Vascular Devices market research report provides company profile for Abbott Vascular, Bayer Healthcare, Volcano Corporation, Teleflex Medical and Others.
This market study includes data about consumer perspective, comprehensive analysis, statistics, market share, company performances (Stocks), historical analysis 2012 to 2017, market forecast 2018 to 2025 in terms of volume, revenue, YOY growth rate, and CAGR for the year 2018 to 2025, etc. The report also provides detailed segmentation…
Peripheral Vascular Device Market Size, Peripheral Vascular Device Market Share, …
Global Peripheral Vascular Device Market Size is observed to gain traction owing to the factors such as increasing research and development for developing several new product, and rising funding by the private organizations.
Request for Sample of This Research Report @ https://bit.ly/2xjOKpC
Top Key Player:-
Abbott Laboratories
Braun Melsungen AG
Boston Scientific Corporation
R. Brad, Inc.
Cardinal Health, Inc.
Medtronic plc.
Cook Medical, Inc.
Teruma Corporation
Jude Medical, Inc.
The Spectranetics Corporation
Volcano Corporation
Peripheral vascular disorder (PVD) is a blood circulation disorder…
Peripheral Artery Disease Market By Type (Peripheral Angioplasty Balloons, Perip …
Peripheral artery disease is characterized by plaque built up in the arteries carrying blood from heart to legs, arms, and other limbs. Peripheral artery disease in turn also increases the risk of other cardiovascular disorders such as heart attack, coronary heart disease, stroke, and ischemic attack.
Request Sample At: https://www.bigmarketresearch.com/request-sample/1633533
The global peripheral artery disease market generated $3,136 million in 2016, and is projected to reach $4,980 million by 2023, registering a…